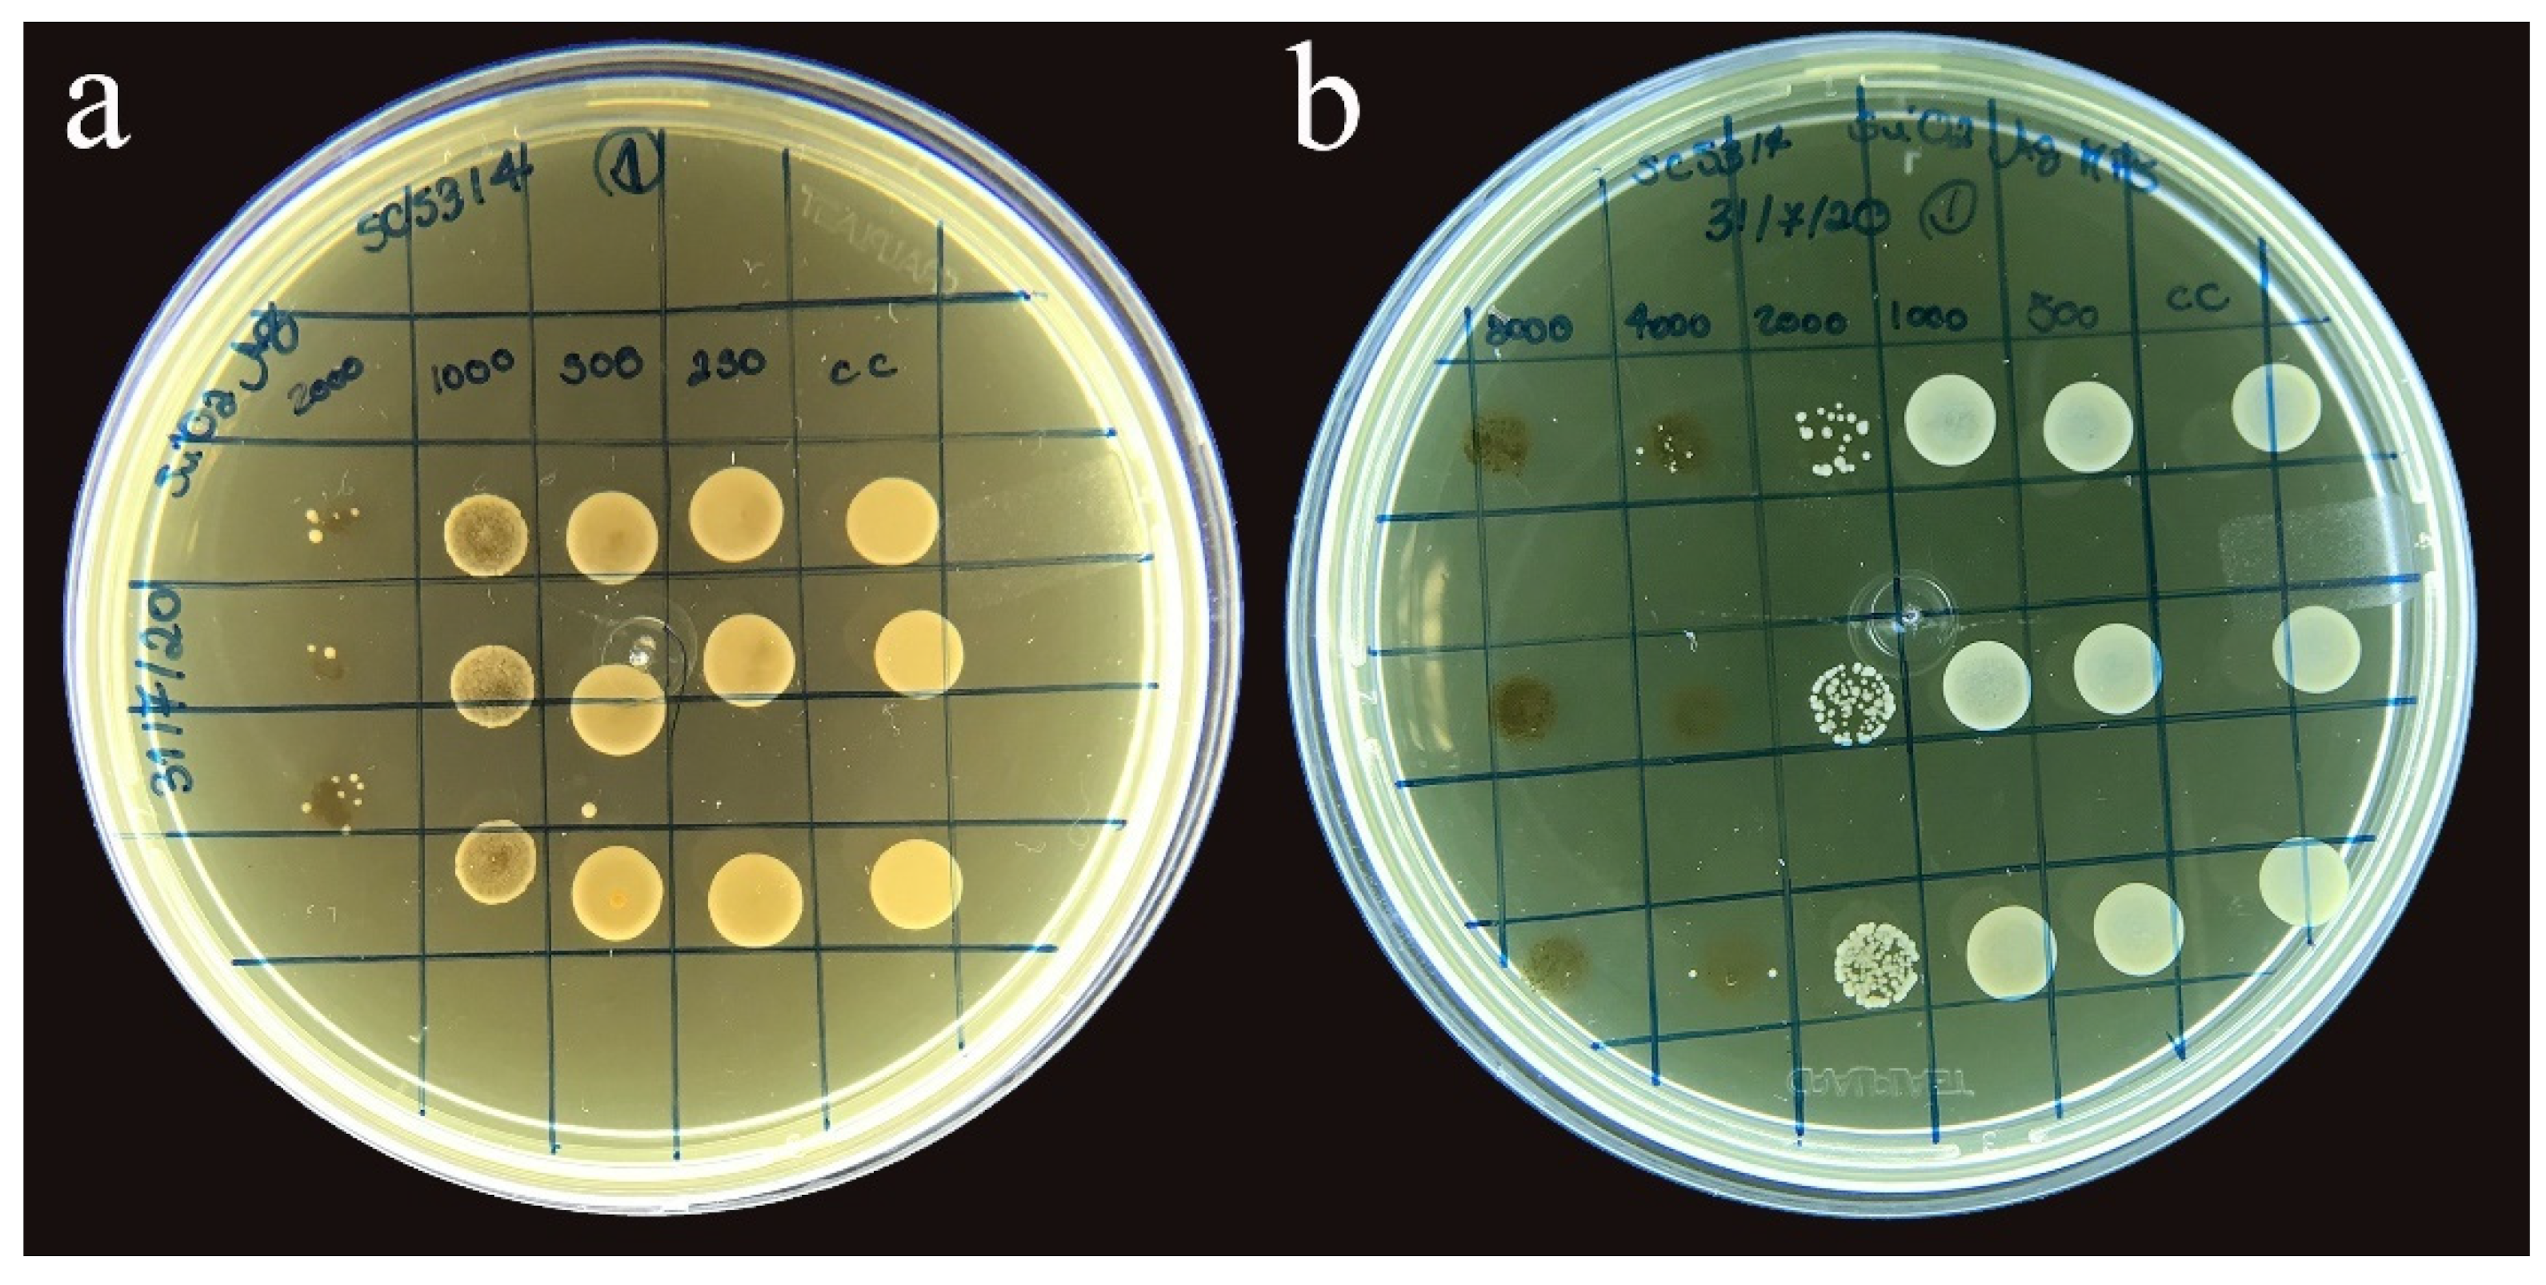
Polymers 14 04306 g005

Silver-Coated Silica Nanoparticles Modified with MPS: Potential Antimicrobial Biomaterials Applied in Glaze and Soft Reliner
Abstract
:1. Introduction
2. Materials and Methods
2.1. Synthesis of SiO2 Nanoparticles
2.2. Silver-Coating of SiO2 Nanoparticles
2.3. Functionalization of SiO2-Ag Nanoparticles Using MPS
2.4. Microstructural Characterization of Nanoparticles
2.5. Minimum Inhibitory Concentration of SiO2-Ag MPS Nanoparticles Solution for Candida albicans
2.6. Preparation of Nanocomposites with the Incorporation of SiO2-Ag-MPS to the Glaze and Soft Reliner
2.7. Microstructural Characterization of Nanocomposites
2.8. Microbiological Characterization of Nanocomposites—Evaluation of the Anti-Biofilm Activity of Candida albicans
2.9. Statistical Analysis
3. Results
3.1. Synthesis of Nanoparticles
3.1.1. Scanning Electron Microscopy—Field Emission Gun (FE-SEM)
3.1.2. Energy Dispersive Scanning Electron Microscopy (SEM-EDX)
3.1.3. X-ray Diffraction (XRD)
3.1.4. Fourier Transform Infrared Spectroscopy (FT-IR)
3.2. Minimum Inhibitory Concentration for Candida albicans (SC 5314)
3.3. Microstructural Characterization of Nanocomposites
3.3.1. Analysis of the Surface of the Nanocomposite by Scanning Electron Microscope (SEM)
3.3.2. Contact Angle and Surface Energy Analysis by Goniometer
3.4. Microbiological Characterization of Nanocomposites—Evaluation of the Anti-Biofilm Activity of Candida albicans
4. Discussion
5. Conclusions
Author Contributions
Funding
Institutional Review Board Statement
Informed Consent Statement
Data Availability Statement
Conflicts of Interest
References
- Gopalakrishnan, S.; Mathew, T.A.; Mozetič, M.; Jose, J.; Thomas, S.; Kalarikkal, N. Development of biocompatible and biofilm-resistant silver-poly(methylmethacrylate) nanocomposites for stomatognathic rehabilitation. Int. J. Polym. Mater. Polym. Biomater. 2019, 69, 186–199. [Google Scholar] [CrossRef]
- Anusavice, K.; Shen, C. Phillips Materiais Dentários, 12th ed.; Elsevier: Rio de Janeiro, Brazil, 2013. [Google Scholar]
- Dorocka-Bobkowska, B.; Medynski, D.; Prylinski, M. Recent Advances in Tissue Conditioners for Prosthetic Treatment. A review. Adv. Clin. Exp. Med. 2017, 26, 723–728. [Google Scholar] [CrossRef] [PubMed] [Green Version]
- Iqbal, Z.; Zafar, M.S. Role of antifungal medicaments added to tissue conditioners: A systematic review. J. Prosthodont. Res. 2016, 60, 231–239. [Google Scholar] [CrossRef] [PubMed]
- Hamid, S.-K.; Al-Dubayan, A.-H.; Al-Awami, H.; Khan, S.; Gad, M.-M. In vitro assessment of the antifungal effects of neem powder added to polymethyl methacrylate denture base material. J. Clin. Exp. Dent. 2019, 11, e170–e178. [Google Scholar] [CrossRef] [PubMed]
- Gendreau, L.; Loewy, Z.G. Epidemiology and Etiology of Denture Stomatitis. J. Prosthodont. 2011, 20, 251–260. [Google Scholar] [CrossRef]
- De Castro, D.T.; Valente, M.L.; Agnelli, J.A.M.; da Silva, C.H.L.; Watanabe, E.; Siqueira, R.L.; Alves, O.L.; Holtz, R.D.; dos Reis, A.C. In vitro study of the antibacterial properties and impact strength of dental acrylic resins modified with a nanomaterial. J. Prosthet. Dent. 2015, 115, 238–246. [Google Scholar] [CrossRef]
- De Castro, D.T.; Valente, M.L.; da Silva, C.H.; Watanabe, E.; Siqueira, R.L.; Schiavon, M.A.; Alves, O.L.; dos Reis, A.C. Evaluation of antibiofilm and mechanical properties of new nanocomposites based on acrylic resins and silver vanadate nanoparticles. Arch. Oral Biol. 2016, 67, 46–53. [Google Scholar] [CrossRef]
- Sabbagh, F.; Kiarostami, K.; Khatir, N.M.; Rezania, S.; Muhamad, I.I.; Hosseini, F. Effect of zinc content on structural, functional, morphological, and thermal properties of kappa-carrageenan/NaCMC nanocomposites. Polym. Test. 2020, 93, 106922. [Google Scholar] [CrossRef]
- Gad, M.M.; Bahgat, H.A.; Edrees, M.F.; Alhumaidan, A.; Khan, S.Q.; Ayad, N.M. Antifungal Activities and Some Surface Characteristics of Denture Soft Liners Containing Silicon Dioxide Nanoparticles. J. Int. Soc. Prev. Community Dent. 2005, 12, 34–37. [Google Scholar] [CrossRef]
- Khatir, N.M.; Abdul-Malek, Z.; Zak, A.K.; Akbari, A.; Sabbagh, F. Sol–gel grown Fe-doped ZnO nanoparticles: Antibacterial and structural behaviors. J. Sol-Gel Sci. Technol. 2015, 78, 91–98. [Google Scholar] [CrossRef]
- Sabbagh, F.; Kiarostami, K.; Khatir, N.M.; Rezania, S.; Muhamad, I.I. Green Synthesis of Mg0.99 Zn0.01O Nanoparticles for the Fabrication of κ-Carrageenan/NaCMC Hydrogel in order to Deliver Catechin. Polymers 2020, 12, 861. [Google Scholar] [CrossRef] [PubMed] [Green Version]
- Chladek, G.; Mertas, A.; Barszczewska-Rybarek, I.; Nalewajek, T.; Żmudzki, J.; Król, W.; Łukaszczyk, J. Antifungal Activity of Denture Soft Lining Material Modified by Silver Nanoparticles—A Pilot Study. Int. J. Mol. Sci. 2011, 12, 4735–4744. [Google Scholar] [CrossRef] [PubMed] [Green Version]
- Welles, A. Silver Nanoparticles: Properties, Characterization and Applications, 1st ed.; Nova Science Publishers: Hauppauge, NY, USA, 2010. [Google Scholar]
- El-Nour, K.M.A.; Eftaiha, A.; Al-Warthan, A.; Ammar, R.A. Synthesis and applications of silver nanoparticles. Arab. J. Chem. 2010, 3, 135–140. [Google Scholar] [CrossRef] [Green Version]
- Khatir, N.M.; Sabbagh, F. Green Facile Synthesis of Silver-Doped Zinc Oxide Nanoparticles and Evaluation of Their Effect on Drug Release. Materials 2022, 15, 5536. [Google Scholar] [CrossRef] [PubMed]
- Durán, N.; Marcato, P.D.; De Souza, G.I.H.; Alves, O.L.; Esposito, E. Antibacterial Effect of Silver Nanoparticles Produced by Fungal Process on Textile Fabrics and Their Effluent Treatment. J. Biomed. Nanotechnol. 2007, 3, 203–208. [Google Scholar] [CrossRef] [Green Version]
- Nischala, K.; Rao, T.N.; Hebalkar, N. Silica–silver core–shell particles for antibacterial textile application. Colloids Surf. B Biointerfaces 2011, 82, 203–208. [Google Scholar] [CrossRef]
- Habibzadeh, S.; Omidvaran, A.; Eskandarion, S.; Shamshiri, A.R. Effect of Incorporation of Silver Nanoparticles on the Tensile Bond Strength of a Long term Soft Denture Liner. Eur. J. Dent. 2020, 14, 268–273. [Google Scholar] [CrossRef]
- Le, T.T.; Nguyen, T.V.; Nguyen, T.A.; Nguyen, T.T.H.; Thai, H.; Tran, D.L.; Dinh, D.A.; Lu, L.T. Thermal, mechanical and antibacterial properties of water-based acrylic Polymer/SiO2–Ag nanocomposite coating. Mater. Chem. Phys. 2019, 232, 362–366. [Google Scholar] [CrossRef]
- Devi, P.; Patil, S.D.; Jeevanandam, P.; Navani, N.K.; Singla, M.L. Synthesis, characterization and bactericidal activity of silica/silver core–shell nanoparticles. J. Mater. Sci. Mater. Electron. 2014, 25, 1267–1273. [Google Scholar] [CrossRef]
- Xu, K.; Wang, J.-X.; Kang, X.-L.; Chen, J.-F. Fabrication of antibacterial monodispersed Ag–SiO2 core–shell nanoparticles with high concentration. Mater. Lett. 2009, 63, 31–33. [Google Scholar] [CrossRef]
- Tang, S.; Tang, Y.; Zhu, S.; Lu, H.; Meng, X. Synthesis and characterization of silica–silver core–shell composite particles with uniform thin silver layers. J. Solid State Chem. 2007, 180, 2871–2876. [Google Scholar] [CrossRef]
- De Menezes, B.R.C.; Sampaio, A.D.G.; da Silva, D.M.; Montanheiro, T.L.D.A.; Koga-Ito, C.Y.; Thim, G.P. AgVO3 nanorods silanized with γ-MPS: An alternative for effective dispersion of AgVO3 in dental acrylic resins improving the mechanical properties. Appl. Surf. Sci. 2020, 543, 148830. [Google Scholar] [CrossRef]
- Stober, W.; Fink, A. Controlled growth of monodisperse silica spheres in the micron size range. J. Colloid. Interface. Sci. 1968, 26, 62–69. [Google Scholar] [CrossRef]
- CLSI. Reference Method for Broth Dilution Antifungal Susceptibility Testing of Yeasts. Approved Standard—Third Edition; CLSI Doc. M27-A3; Clinical and Laboratory Standards Institute: Wayne, PA, USA, 2008; Available online: https://clsi.org/media/1461/m27a3_sample.pdf (accessed on 23 August 2022).
- Jasiorski, M.; Leszkiewicz, A.; Brzeziński, S.; Bugla-Płoskońska, G.; Malinowska, G.; Borak, B.; Karbownik, I.; Baszczuk, A.; Stręk, W.; Doroszkiewicz, W. Textile with silver silica spheres: Its antimicrobial activity against Escherichia coli and Staphylococcus aureus. J. Sol-Gel Sci. Technol. 2009, 51, 330–334. [Google Scholar] [CrossRef]
- Díaz-Benito, B.; Velasco, F.; Pantoja, M. Mechanical properties of polyester films painted after silanization of 6063 aluminium alloy with different pretreatment conditions. Prog. Org. Coatings 2011, 70, 287–292. [Google Scholar] [CrossRef]
- Sarasini, F.; Tirillò, J.; Lilli, M.; Bracciale, M.P.; Vullum, P.E.; Berto, F.; De Bellis, G.; Tamburrano, A.; Cavoto, G.; Pandolfi, F.; et al. Highly aligned growth of carbon nanotube forests with in-situ catalyst generation: A route to multifunctional basalt fibres. Compos. Part B Eng. 2022, 243, 110136. [Google Scholar] [CrossRef]
- Gholami, T.; Salavati-Niasari, M.; Bazarganipour, M.; Noori, E. Synthesis and characterization of spherical silica nanoparticles by modified Stöber process assisted by organic ligand. Superlattices Microstruct. 2013, 61, 33–41. [Google Scholar] [CrossRef]
- Hu, Q.; Suzuki, H.; Gao, H.; Araki, H.; Yang, W.; Noda, T. High-frequency FTIR absorption of SiO2/Si nanowires. Chem. Phys. Lett. 2003, 378, 299–304. [Google Scholar] [CrossRef]
- Yu, L.-Y.; Xu, Z.-L.; Shen, H.-M.; Yang, H. Preparation and characterization of PVDF–SiO2 composite hollow fiber UF membrane by sol–gel method. J. Membr. Sci. 2009, 337, 257–265. [Google Scholar] [CrossRef]
- Sakthisabarimoorthi, A.; Dhas, S.M.B.; Jose, M. Fabrication and nonlinear optical investigations of SiO2@Ag core-shell nanoparticles. Mater. Sci. Semicond. Process. 2017, 71, 69–75. [Google Scholar] [CrossRef]
- Holtz, R.D.; Filho, A.G.S.; Brocchi, M.; Martins, D.; Durán, N.; Alves, O.L. Development of nanostructured silver vanadates decorated with silver nanoparticles as a novel antibacterial agent. Nanotechnology 2010, 21, 185102. [Google Scholar] [CrossRef] [PubMed]
- Sajan, D.; Sockalingum, G.D.; Manfait, M.; Joe, I.H.; Jayakumar, V.S. NIR-FT Raman, FT-IR and surface-enhanced Raman scattering spectra, with theoretical simulations on chloramphenicol. J. Raman Spectrosc. 2008, 39, 1772–1783. [Google Scholar] [CrossRef]
- Krishnan, V.; Bupesh, G.; Manikandan, E.; Thanigai, A.K.; Magesh, S.; Kalyanaraman, R.; Maaza, M. Green Synthesis of Silver Nanoparticles Using Piper nigrum Concoction and its Anticancer Activity against MCF-7 and Hep-2 Cell Lines. J. Antimicrob. Agents 2016, 2, 2472-1212. [Google Scholar] [CrossRef]
- Tang, S.; Tang, Y.; Gao, F.; Liu, Z.; Meng, X. Ultrasonic electrodeposition of silver nanoparticles on dielectric silica spheres. Nanotechnology 2007, 18, 295607. [Google Scholar] [CrossRef]
- Suzuki, N.; Ishida, H. Acceleration of silanol condensation of a methacryl-functional silane in the model sizing system. Compos. Interfaces 2005, 12, 769–785. [Google Scholar] [CrossRef]
- Abdelmouleh, M.; Boufi, S.; Belgacem, M.N.; Dufresne, A. Short natural-fibre reinforced polyethylene and natural rubber composites: Effect of silane coupling agents and fibres loading. Compos. Sci. Technol. 2007, 67, 1627–1639. [Google Scholar] [CrossRef]
- Rodriguez, M.; Liso, M.; Rubio, F.; Oteo, J. Study of the reaction of (γ-MPS) with slate surfaces. J. Mater. Sci. 1999, 4, 3867–3873. [Google Scholar] [CrossRef]
- Rulkens, R.; Male, J.L.; Terry, K.W.; Olthof, B.; Khodakov, A.; Bell, A.T.; Iglesia, E.; Tilley, T.D. Vanadyl tert-Butoxy Orthosilicate, OV[OSi(OtBu)3]3: A Model for Isolated Vanadyl Sites on Silica and a Precursor to Vanadia−Silica Xerogels. Chem. Mater. 1999, 11, 2966–2973. [Google Scholar] [CrossRef]
- Rice, G.L.; Scott, S.L. Site-specific oxygen-18 labelling of silica-supported vanadium(V) complexes: Implications for oxidation catalysis. J. Mol. Catal. A: Chem. 1997, 125, 73–79. [Google Scholar] [CrossRef]
- Marin, S.; Vlasceanu, G.M.; Tiplea, R.E.; Bucur, I.R.; Lemnaru, M.; Marin, M.M.; Grumezescu, A.M. Applications and Toxicity of Silver Nanoparticles: A Recent Review. Curr. Top. Med. Chem. 2015, 15, 1596–1604. [Google Scholar] [CrossRef]
- Barbasz, A.; Oćwieja, M.; Roman, M. Toxicity of silver nanoparticles towards tumoral human cell lines U-937 and HL-60. Colloids Surf. B Biointerfaces 2017, 156, 397–404. [Google Scholar] [CrossRef] [PubMed]
- Hadrup, N.; Lam, H.R. Oral toxicity of silver ions, silver nanoparticles and colloidal silver—A review. Regul. Toxicol. Pharmacol. 2014, 68, 1–7. [Google Scholar] [CrossRef] [PubMed]
- Bamal, D.; Singh, A.; Chaudhary, G.; Kumar, M.; Singh, M.; Rani, N.; Mundlia, P.; Sehrawat, A.R. Silver Nanoparticles Biosynthesis, Characterization, Antimicrobial Activities, Applications, Cytotoxicity and Safety Issues: An Updated Review. Nanomaterials 2021, 11, 2086. [Google Scholar] [CrossRef] [PubMed]
- Nikzamir, M.; Akbarzadeh, A.; Panahi, Y. An overview on nanoparticles used in biomedicine and their cytotoxicity. J. Drug Deliv. Sci. Technol. 2020, 61, 102316. [Google Scholar] [CrossRef]
- Corrêa, J.M.; Mori, M.; Sanches, H.L.; Cruz, A.; Poiate, E.; Poiate, I.A.V.P. Silver Nanoparticles in Dental Biomaterials. Int. J. Biomater. 2015, 2015, 485275. [Google Scholar] [CrossRef] [Green Version]
- Lu, M.-M.; Wang, Q.-J.; Chang, Z.-M.; Wang, Z.; Zheng, X.; Shao, D.; Dong, W.-F.; Zhou, Y.-M. Synergistic bactericidal activity of chlorhexidine-loaded, silver-decorated mesoporous silica nanoparticles. Int. J. Nanomed. 2017, 12, 3577–3589. [Google Scholar] [CrossRef] [Green Version]
- Pal, S.; Tak, Y.K.; Song, J.M. Does the Antibacterial Activity of Silver Nanoparticles Depend on the Shape of the Nanoparticle? A Study of the Gram-Negative Bacterium Escherichia coli. Appl. Environ. Microbiol. 2007, 73, 1712–1720. [Google Scholar] [CrossRef] [Green Version]
- Martínez-Castañón, G.A.; Niño-Martínez, N.; Martínez-Gutierrez, F.; Martínez-Mendoza, J.R.; Ruiz, F. Synthesis and antibacterial activity of silver nanoparticles with different sizes. J. Nanoparticle Res. 2008, 10, 1343–1348. [Google Scholar] [CrossRef]
- Mohammed, D.H.; Tukmachi, M.S.; Safi, I.N. Characterizations and testing some mechanical properties of prepared PMMA-Lithium disilicate glass ceramic composite for denture base application. Mater. Today Proc. 2021, 42, 2482–2489. [Google Scholar] [CrossRef]
- Plueddemann, E. Silane Coupling Agent, 2nd ed.; Springer: New York, NY, USA, 1991. [Google Scholar]
- Tsukeoka, T.; Suzuki, M.; Ohtsuki, C.; Sugino, A.; Tsuneizumi, Y.; Miyagi, J.; Kuramoto, K.; Moriya, H. Mechanical and histological evaluation of a PMMA-based bone cement modified with γ-methacryloxypropyltrimethoxysilane and calcium acetate. Biomaterials 2006, 27, 3897–3903. [Google Scholar] [CrossRef]
- Hassler, C.; von Metzen, R.P.; Ruther, P.; Stieglitz, T. Characterization of parylene C as an encapsulation material for implanted neural prostheses. J. Biomed. Mater. Res. Part B Appl. Biomater. 2010, 9999B, 266–274. [Google Scholar] [CrossRef] [PubMed]
- Qasim, M.; Singh, B.R.; Naqvi, A.H.; Paik, P.; Das, D. Silver nanoparticles embedded mesoporous SiO2 nanosphere: An effective anticandidal agent against Candida albicans 077. Nanotechnology 2015, 26, 285102. [Google Scholar] [CrossRef] [PubMed]
- Majeed, H.M.; Wadee, S.A. Antibacterial Activity and Mechanism of Nickel Nanoparticles against Multidrug Resistant Pseudomonas aeruginosa. Ann. Trop. Med. Public Health 2019, 22, 1469–1487. [Google Scholar] [CrossRef]
- Bahrami-Teimoori, B.; Nikparast, Y.; Hojatianfar, M.; Akhlaghi, M.; Ghorbani, R.; Pourianfar, H.R. Characterisation and antifungal activity of silver nanoparticles biologically synthesised by Amaranthus retroflexus leaf extract. J. Exp. Nanosci. 2017, 12, 129–139. [Google Scholar] [CrossRef] [Green Version]
- Sacorague, S. Avaliação Mecânica e Microbiológica de Resinas Acrílicas Reforçadas com Partículas de Sílica Revestidas Com Prata; Instituto de Ciência e Tecnologia, UNESP-University Estadual Paulista: São José dos Campos, Brazil, 2016. [Google Scholar]
- Ziąbka, M.; Dziadek, M. Thermoplastic Polymers with Nanosilver Addition—Microstructural, Surface and Mechanical Evaluation during a 36-Month Deionized Water Incubation Period. Materials 2021, 14, 361. [Google Scholar] [CrossRef]
- De Menezes, B.R.C.; Sampaio, A.D.G.; da Silva, D.M.; Montagna, L.S.; Montanheiro, T.L.D.A.; Ito, C.Y.K.; Thim, G.P. Nanocomposites obtained by incorporation of silanized silver nanowires to improve mechanical properties and prevent fungal adhesion. Nano Sel. 2021, 2, 2358–2372. [Google Scholar] [CrossRef]
- Li, Z.; Sun, J.; Lan, J.; Qi, Q. Effect of a denture base acrylic resin containing silver nanoparticles on Candida albicans adhesion and biofilm formation. Gerodontology 2014, 33, 209–216. [Google Scholar] [CrossRef]
- Panáček, A.; Kolář, M.; Večeřová, R.; Prucek, R.; Soukupová, J.; Kryštof, V.; Hamal, P.; Zbořil, R.; Kvítek, L. Antifungal activity of silver nanoparticles against Candida spp. Biomaterials 2009, 30, 6333–6340. [Google Scholar] [CrossRef] [PubMed]
- Żarowska, B.; Koźlecki, T.; Piegza, M.; Jaros-Koźlecka, K.; Robak, M. New Look on Antifungal Activity of Silver Nanoparticles (AgNPs). Pol. J. Microbiol. 2019, 68, 515–525. [Google Scholar] [CrossRef]

| Groups (n = 12) | Description |
|---|---|
| CG | Glaze + Soft reliner |
| G1 | (Glaze + SiO2-Ag-MPS nanoparticles 1 wt%) + Soft reliner |
| G2 | (Glaze + SiO2-Ag-MPS nanoparticles 2.5 wt%) + Soft reliner |
| Groups (n = 12) | Description |
|---|---|
| CR | Soft reliner |
| R1 | Soft reliner + SiO2-Ag-MPS 1 wt% nanoparticles |
| R2 | Soft reliner + SiO2-Ag-MPS 2.5 wt% nanoparticles |
| Element | SiO2 | SiO2-Ag | SiO2-Ag-MPS | |||
|---|---|---|---|---|---|---|
| wt% | at% | wt% | at% | wt% | at% | |
| C | 1.2 | 1.9 | 6.7 | 13.5 | 2.0 | 4.3 |
| O | 54.1 | 66.7 | 4.5 | 62.9 | 35.2 | 61.5 |
| Si | 44.7 | 31.5 | 18.6 | 16.1 | 23.6 | 23.9 |
| Ag | - | - | 33.2 | 7.5 | 38.2 | 10.4 |
| Sample | Bands (cm−1) | Assignment | Reference |
|---|---|---|---|
| 1627 | H2O vibration | [34] | |
| SiO2 | 1169 | Asymmetric stretching vibration of the Si-O bond | [31] |
| 1054 | Asymmetric stretching vibration of Si-O-Si bonds | [31] | |
| 951 | Si-OH asymmetric stretching vibration | [32,33] | |
| 794 | Bending mode (torsion) | [31] | |
| SiO2-Ag | 1636 | H2O vibration | [34] |
| 1383 | Symmetric stretching vibration of N=O bond | [33] | |
| 1328 | Symmetric stretching vibration of N=O bond | [33] | |
| 1194 | Asymmetric stretching vibration of the Si-O bond | [31] | |
| 1080 | Asymmetric stretching vibration of Si-O-Si bonds | [31] | |
| 955 | Si-OH asymmetric stretching vibration | [32,33] | |
| 777 | Bending mode (torsion) | [31] | |
| SiO2-Ag-MPS | 1717 | Stretching vibration of C=C | [39,40] |
| 1630 | H2O vibration | [34] | |
| 1321 | Symmetric stretching vibration of C-O-C bond | [38,39] | |
| 1295 | Symmetric stretching vibration of C-O bond | [38,39] | |
| 1158 | Asymmetric stretching vibration of the Si-O bond | [31] | |
| 1059 | Asymmetric stretching vibration of Si-O-Si bonds | [31] | |
| 930 | Si-OH asymmetric stretching vibration | [31] | |
| 783 | Bending mode (torsion) | [31] |
| Groups | Mean ± Standard Deviation | Tukey’s Test |
|---|---|---|
| CG | 53.3 ± 11.0 | B |
| G1 | 57.2 ± 10.6 | B |
| G2 | 73.7 ± 12.1 | A |
| Groups | Mean ± Standard Deviation | Tukey’s Test |
|---|---|---|
| CR | 35.6 ± 10.9 | B |
| R1 | 44.8 ± 7.8 | B |
| R2 | 57.9 ± 10.7 | A |
| Groups | n | Median | Ave Rank | Z-Value |
|---|---|---|---|---|
| CG | 12 | 1,300,000 | 20.7 | 0.87 |
| G1 | 12 | 470,000 | 14.3 | −1.68 |
| G2 | 12 | 1,150,000 | 20.5 | 0.81 |
| Overall | 36 | 18.5 |
| Groups | n | Median | Ave Rank | Z-Value |
|---|---|---|---|---|
| CR | 12 | 470,000 | 17.0 | −0.59 |
| R1 | 12 | 475,000 | 16.0 | −1.02 |
| R2 | 12 | 1,150,000 | 22.5 | 1.61 |
| Overall | 36 | 18.5 |
Publisher’s Note: MDPI stays neutral with regard to jurisdictional claims in published maps and institutional affiliations. |
© 2022 by the authors. Licensee MDPI, Basel, Switzerland. This article is an open access article distributed under the terms and conditions of the Creative Commons Attribution (CC BY) license (https://creativecommons.org/licenses/by/4.0/).
Share and Cite
Rossi, N.R.; de Menezes, B.R.C.; Sampaio, A.d.G.; da Silva, D.M.; Koga-Ito, C.Y.; Thim, G.P.; Paes-Junior, T.J.d.A. Silver-Coated Silica Nanoparticles Modified with MPS: Potential Antimicrobial Biomaterials Applied in Glaze and Soft Reliner. Polymers 2022, 14, 4306. https://doi.org/10.3390/polym14204306
Rossi NR, de Menezes BRC, Sampaio AdG, da Silva DM, Koga-Ito CY, Thim GP, Paes-Junior TJdA. Silver-Coated Silica Nanoparticles Modified with MPS: Potential Antimicrobial Biomaterials Applied in Glaze and Soft Reliner. Polymers. 2022; 14(20):4306. https://doi.org/10.3390/polym14204306
Chicago/Turabian StyleRossi, Natália Rivoli, Beatriz Rossi Canuto de Menezes, Aline da Graça Sampaio, Diego Morais da Silva, Cristiane Yumi Koga-Ito, Gilmar Patrocínio Thim, and Tarcisio José de Arruda Paes-Junior. 2022. "Silver-Coated Silica Nanoparticles Modified with MPS: Potential Antimicrobial Biomaterials Applied in Glaze and Soft Reliner" Polymers 14, no. 20: 4306. https://doi.org/10.3390/polym14204306
APA StyleRossi, N. R., de Menezes, B. R. C., Sampaio, A. d. G., da Silva, D. M., Koga-Ito, C. Y., Thim, G. P., & Paes-Junior, T. J. d. A. (2022). Silver-Coated Silica Nanoparticles Modified with MPS: Potential Antimicrobial Biomaterials Applied in Glaze and Soft Reliner. Polymers, 14(20), 4306. https://doi.org/10.3390/polym14204306







